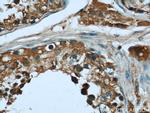
AHCY Antibody in Immunohistochemistry (Paraffin) (IHC (P))
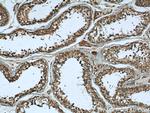
AHCY Antibody in Immunohistochemistry (Paraffin) (IHC (P))

Search
Proteintech
AHCY Monoclonal Antibody (1F9B10)
{{$productOrderCtrl.translations['antibody.pdp.commerceCard.promotion.promotions']}}
{{$productOrderCtrl.translations['antibody.pdp.commerceCard.promotion.viewpromo']}}
{{$productOrderCtrl.translations['antibody.pdp.commerceCard.promotion.promocode']}}: {{promo.promoCode}} {{promo.promoTitle}} {{promo.promoDescription}}. {{$productOrderCtrl.translations['antibody.pdp.commerceCard.promotion.learnmore']}}
产品信息
66019-1-IG
种属反应
宿主/亚型
分类
类型
克隆号
抗原
偶联物
形式
浓度
规格
纯化类型
保存液
内含物
保存条件
运输条件
产品详细信息
Immunogen sequence: QTLYFKDGP LNMILDDGGD LTNLIHTKYP QLLPGIRGIS EETTTGVHNL YKMMANGILK VPAINVNDSV TKSKFDNLYG CRESLIDGIK RATDVMIAGK VAVVAGYGDV GKGCAQALRG FGARVIITEI DPINALQAAM EGYEVTTMDE ACQEGNIFVT TTGCIDIILG RHFEQMKDDA IVCNIGHFDV EIDVKWLNEN AVEKVNIKPQ VDRYRLKNGR RIILLAEGRL VNLGCAMGHP SFVMSNSFTN QVMAQIELWT HPDKYPVGVH FLPKKLDEAV AEAHLGKLNV KLTKLTEKQA QYLGMSCDGP FKPDHYRY (116-432 aa encoded by BC011606)
靶标信息
S-adenosylhomocysteine hydrolase (AHCY) catalyzes the reversible hydrolysis of S-adenosylhomocysteine (AdoHcy) to adenosine (Ado) and L-homocysteine (Hcy). Thus, it regulates the intracellular S-adenosylhomocysteine (SAH) concentration thought to be important for transmethylation reactions. Deficiency in this protein is one of the different causes of hypermethioninemia. S-adenosylhomocysteine hydrolase belongs to the adenosylhomocysteinase family.
仅用于科研。不用于诊断过程。未经明确授权不得转售。
生物信息学
蛋白别名: Acetylation; Adenosylhomocysteinase; AdoHcyase; epididymis secretory sperm binding protein; Hydrolase; NAD; Polymorphism; S-adenosyl-L-homocysteine hydrolase; S-adenosylhomocysteine hydrolase; unnamed protein product
基因别名: adoHcyase; AHCY; SAHH
UniProt ID: (Human) P23526
Entrez Gene ID: (Human) 191